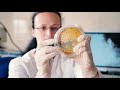

Malestar, vómitos, picor... Son los síntomas más leves que pueden ocasionarte algunos de estos parásitos. Tenia, oxiuros, anquilostomas... no son difíciles de contraer. De hecho, ¡atento! Podrías estar infectado ahora mismo por uno de estos poco agradables huéspedes.
Suscríbete al canal!
Echa un vistazo a nuestras listas de reproducción:
Lugares, países, ciudades y sus curiosidades http://goo.gl/yKb9pD
Salud y bienestar | Curiosidades http://bit.ly/1sA35TZ
Naturaleza y animales | Curiosidades http://bit.ly/1w0iNZc
Personajes famosos | Gente http://bit.ly/1zoZdKL
Curiosidades del mundo ¡Sorprendentes! http://bit.ly/1mId4Yd
Podrías Tener Alguno De Estos PARÁSITOS ─ Haztelalista
<style>.embed-container { position: relative; padding-bottom: 56.25%; height: 0; overflow: hidden; max-width: 100%; } .embed-container iframe, .embed-container object, .embed-container embed { position: absolute; top: 0; left: 0; width: 100%; height: 100%; }</style><div class="embed-container"><iframe src="https://www.youtube.com/embed/Co4bRLbmjmI" frameborder="0" allowfullscreen></iframe></div>